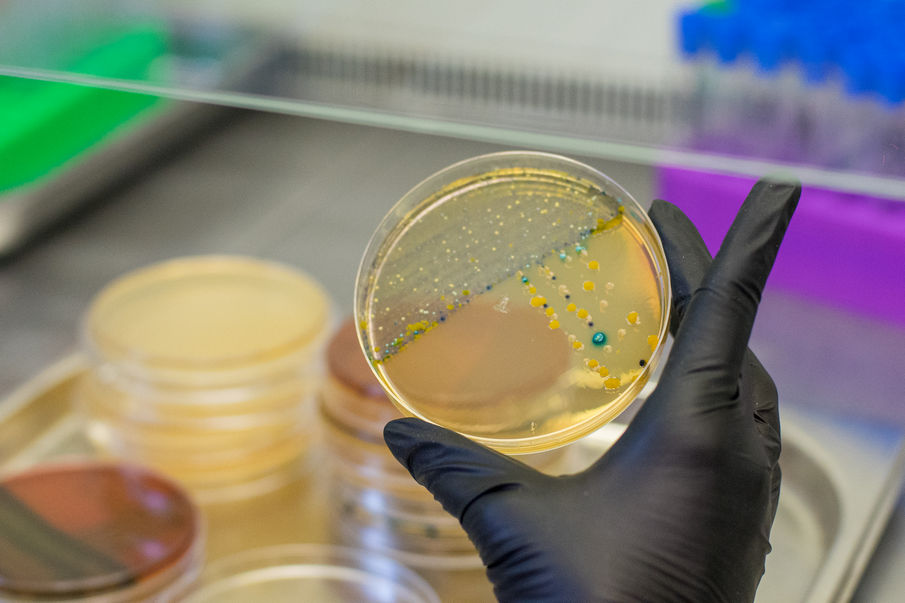
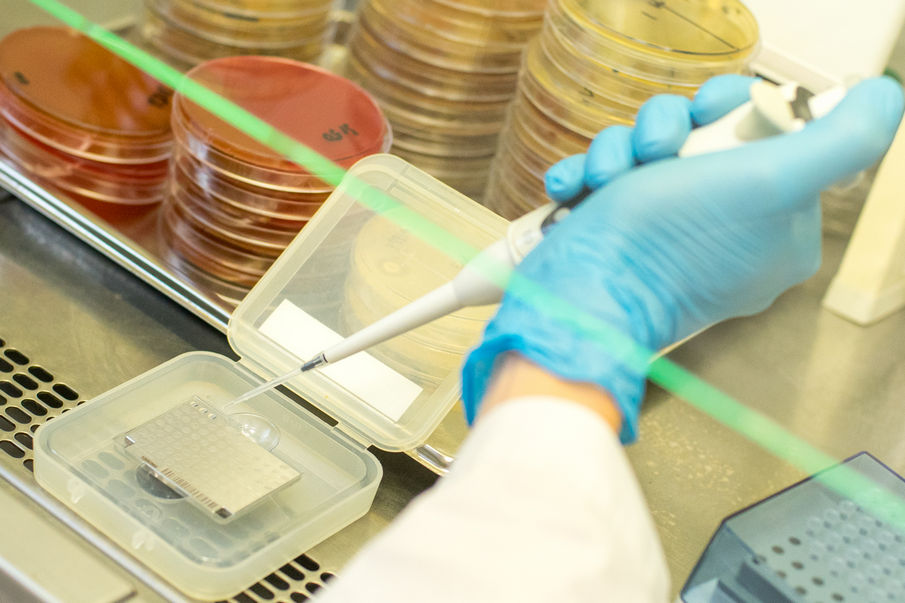

Микробиологическая лаборатория
Микробиологическая лаборатория Клиник СамГМУ (микробиологический отдел клинико-диагностической лаборатории) открыта 26 декабря 2013 года. На сегодняшний день представляет собой высокотехнологичное подразделение, оснащенное современным оборудованием и укомплектованное квалифицированными специалистами. Лаборатория является базой кафедры медицинской микробиологии и иммунологии, кафедры фундаментальной и клинической биохимии с лабораторной диагностикой и научно-образовательного профессионального центра генетических и лабораторных технологий.
Идентификация выделенных бактерий проводится с использованием метода MALDI ToF масс-спектрометрии на приборе Microflex LT (Bruker Daltonik GmbH, Германия). Это современный, быстрый и точный метод идентификации бактерий, основанный на анализе уникального белкового «отпечатка пальца», сравниваемого с различными базами данных микроорганизмов. Это позволило сократить время микробиологических исследований с 7-10 дней до 2-4 дней для большинства проводимых исследований.
Наличие современного оборудования позволило осуществлять значительное количество бактериологических исследований. Ежегодно в микробиологической лаборатории проводится более 15 тыс. бактериологических и микроскопических исследований.
Микробиологические исследования используются для идентификации возбудителя бактериальной инфекции и подбора наиболее эффективного антибактериального препарата для максимально безопасного лечения.
Микробиологическая диагностика бактериальных осложнений у пациентов с муковисцидозом

Перечень предлагаемых услуг:
- Диагностика бактериальных инфекций
- Идентификация потенциальных патогенов
- Определение антибиотикорезистентности
- Профилактические исследования
Показания для проведения исследований:
- Подозрение на инфекционную этиологию заболевания
- Хроническое течение патологического процесса
- Необходимость подбора антибактериальной терапии
- Профилактическое обследование
- Подготовка к хирургическим вмешательствам

Исследования проводятся в рамках обязательного медицинского страхования (ОМС) по направлению формы 057/у, а также на условиях платных медицинских услуг и добровольного медицинского страхования (ДМС).
Результаты микробиологических исследований могут быть отправлены на личную почту (при заполнении согласия на обработку персональных данных) или получены распечатанные результаты при личном посещении микробиологической лаборатории с 9:00 до 14:00 в будние дни.
Маршрутизация
Маршрутизация в случае если биоматериал собран в другом лечебно-профилактическом учреждении или взят (собран) самостоятельно.
Материал доставляется в кабинет приема материала в микробиологической лаборатории после оплаты в регистратуре в инфекционном корпусе на втором этаже. В период с 8:30 до 12:00 в будние дни.

Маршрутизация в случае если биоматериал будет взят (собран) в Клиниках СамГМУ
Взятие биоматериала из ЛОР-органов (мазки из носа, ротоглотки, задней стенки глотки, языка) проводится в 23 кабинете в административном корпусе Клиник СамГМУ и оплачивается в регистратуре в этом же корпусе.

Как нас найти:


Памятка по сбору и транспортировке материала для микробиологического исследования
| Код услуги | Наименование услуги | Стоимость | |
| Бактериологические исследования: | |||
| A26.9401.01 | Сбор материала для микроскопического и микробиологического исследования | 150,00 ₽ | |
| Микробиологические исследования | |||
| A26.9401.05.01 | Посев клинического материала на микрофлору с идентификацией возбудителя и определением чувствительности к антимикробным препаратам | 1 000,00 ₽ | |
| A26.9401.21 | Микробиологическое исследование клинического материала от пациентов с муковисцидозом | 2 000,00 ₽ | |
| A26.05.016.9401.01 | Исследование на дисбактериоз кишечника с идентификацией микрофлоры и определением чувствительности к антимикробным препаратам | 1 900,00 ₽ | |
| A26.9401.09.01 | Исследование на дисбиоз влагалища с идентификацией микрофлоры и определением чувствительности к антимикробным препаратам | 1 900,00 ₽ | |
| A26.04.004 | Микробиологическое (культуральное) исследование синовиальной жидкости на аэробные и факультативно-анаэробные микроорганизмы | 1 700,00 ₽ | |
| A26.05.001.9401.01 | Посев крови на стерильность с идентификацией возбудителя и определением чувствительности к антимикробным препаратам | 1 500,00 ₽ | |
| A26.9401.05 | Посев клинического материала на микрофлору с идентификацией возбудителя | 700,00 ₽ | |
| A26.9401.08 | Исследование клинического материала на золотистый стафилококк | 400,00 ₽ | |
| A26.9401.08.01 | Исследование клинического материала на золотистый стафилококк с определением чувствительности к антимикробным препаратам | 700,00 ₽ | |
| A26.30.006 | Определение чувствительности микроорганизмов к бактериофагам | 400,00 ₽ | |
| A26.9401.10 | Исследование клинического материала на грибы с идентификацией возбудителя | 400,00 ₽ | |
| A26.9401.10.01 | Исследование клинического материала на грибы с идентификацией возбудителя и определением чувствительности к антимикотикам | 800,00 ₽ | |
| A26.30.004.001 | Определение чувствительности микроорганизмов к антимикробным химиотерапевтическим препаратам диско-диффузионным методом | 400,00 ₽ | |
| A26.9401.11 | Определение минимальной подавляющей концентрации (МПК) к антимикробным препаратам у выделенной микрофлоры | 1 400,00 ₽ | |
| A26.9401.12 | Исследование клинического материала на анаэробную микрофлору с идентификацией возбудителя | 1 400,00 ₽ | |
| Микроскопические исследования | |||
| A26.9401.02 | Микроскопическое исследование клинического материала на микрофлору (окраска по Граму) | 350,00 ₽ | |
| A26.9401.03 | Микроскопическое исследование клинического материала на грибы | 300,00 ₽ | |
| A26.9401.14 | Микроскопическое исследование на пневмоцисты | 950,00 ₽ | |
| Масс-спектрометрия | |||
| A26.9401.20 | Идентификация микроорганизмов методом масс-спектрометрии | 150,00 ₽ | |
| A26.9401.20.01 | Идентификация микроорганизмов методом масс-спектрометрии с экстракцией белков | 400,00 ₽ | |
Отзывы
Уважаемы Армен Сисакович!
Самарское обделение МОО «Помощь больным муковисцидозом» поздравляет Вас и Ваших сотрудников с Днем медицинского работника!
Выражаем огромную благодарность врачам-бактериологам Микробиологического отдела КДЛ Клиник СамГМУ — д.м.н., доцентам кафедры общей и клинической микробиологии, иммунологии и аллергологии ФГБОУ ВО СамГМУ Минзрава России — Артему Викторовичу Лямину и Ольге Владимировне Кондратенко за высокий профессионализм, активную научно-исследовательскую деятельность и неравнодушие! Огромное спасибо!

Уважаемый Александр Владимирович!
Благотворительный фонд «Острова» выражает признательность сотрудникам ФГБОУ ВО «Самарский государственный медицинский университет» за участие в подготовке и проведении Х ежегодной Северо-Западной научно-практической конференции по муковисцидозу «Антимикробная терапия при муковисцидозе: микробиологические аспекты», которая состоялась 9-10 апреля 2021г. в Санкт-Петербурге:
Лямину Артему Викторовичу, доценту кафедры общей и клинической микробиологии, иммунологии и аллергологии ФГБОУ ВО СамГМУ Минздрава России, врачу-бактериологу микробиологического отдела КДЛ Клиник ФГБОУ ВО СамГМУ Минздрава России, к.м.н., за модерацию интерактивных секций в первый день конференции «Частые аспекты применения антибиотиков: муковисцидоз» и подготовку докладов на темы: «Микробиологические аспекты ингаляционной терапии» и «Медицинская микробиология: новые нормативные документы»;
Кондратенко Ольге Владимировне, доценту кафедры общей и клинической микробиологии, иммунологии и аллергологии ФГБОУ ВО СамГМУ Минздрава России, врачу-бактериологу микробиологического отдела КДЛ Клиник ФГБОУ ВО СамГМУ Минздрава России, к.м.н., за модерацию интерактивной секции во второй день конференции «Организация и проведение микробиологического исследования при муковисцидозе: учитываем особенности, преодолеваем трудности и подготовку докладов на темы: «Новые антибиотики в терапии инфекций, вызванных полирезистентной микрофлорой: что есть, что будет?» и «Микробиологическое исследование при муковисцидозе: от выбора сред до выдачи заключения».
Искренне надеемся на продолжение плодотворного сотрудничества и будем рады видеть сотрудников Университета на наших будущих мероприятиях.
